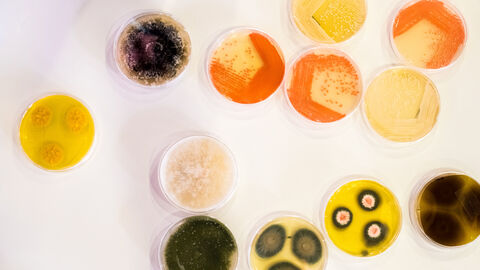
Kultur von Bakterien in einer Petrischale Unterschiedlich farbige Bakterienkolonien in Petrischalen

Obwohl Tularämie („Hasenpest“), d.h. die Infektion mit dem Bakterium Francisella tularensis, primär eine tödlich verlaufende Erkrankung bestimmter kleiner Säugetiere wie Kaninchen, Hase, Fuchs und Dachs ist, können sich auch Menschen mit diesem Erreger anstecken und schwer erkranken. Es handelt sich deshalb um eine sogenannte Zoonose. Auch andere Wild-, Haus- und Nutztiere können sich infizieren. Die Erkrankung ist in Deutschland nach dem Infektionsschutzgesetz und einer auf dem Tiergesundheitsgesetz basierenden Verordnung meldepflichtig.
Fachartikel
Wissenswertes aus der Bakteriologie & Mykologie
Bakteriologie
Rückkehr der Biber – Ergebnisse aus dem Wildtiermonitoring
Der Europäische Biber wurde nach fast vollständiger Ausrottung auch in Deutschland wieder angesiedelt. Wie alle Wildtiere werden die geschützten Biber im Rahmen des amtlichen Wildtiermonitorings beobachtet und auf Todes- und Krankheitsursachen untersucht, mit einem überraschenden Ergebnis: erstmalig wurde Corynebacterium (C.) ulcerans gleich bei drei tot aufgefundenen Bibernn isoliert.
Bakteriologie
Corynebacterium rouxii: Auslöser für Hautveränderungen bei Hunden
Corynebacterium (C.) diphtheriae, ist der Erreger der Diphtherie des Menschen, einer nach wie vor weltweit mit hohen Erkrankungs- und Sterblichkeitsraten einhergehenden Infektionskrankheit. Tiere galten bis dato als nicht besonders empfänglich für diesen Erreger, weshalb man auch keine Zoonosegefahr mutmaßte.
Bakteriologie
Meisensterben in Hessen — Nachweis von Suttonella ornithocola spricht für bakterielle Infektion
In Hessen wird seit dem Frühjahr 2020 ein vermehrtes Meisensterben beobachtet. Untersuchungen des Hessischen Landeslabors zufolge ist dafür eine Infektion mit dem Bakterium Suttonella ornithocola verantwortlich. Eine Gefährung von Menschen oder anderen Tieren besteht nicht. Wissenschaftler des Landeslabors haben die Diagnostik der Erkrankung optimiert.
Bakteriologie
Who is Who? Identifizierung von Bakterien und Pilzen in der Routinediagnostik
Mit klassischen Bestimmungsmethoden kommt man bei der Identifizierung von Bakterien und Pilzen oft nicht weiter, so dass erst der Blick auf den genetischen Code den Durchblick bringt. Hierfür haben wir zusätzliche, rasche und kostengünstige molekularbiologische Methoden zur Identifizierung von Bakterien und Pilzen in die Diagnostik eingeführt.
Bakteriologie
Corynebacterium ulcerans beim Igel: Neue Ergebnisse aus belgischer Studie lassen aufhorchen
Wildlebende Igel können sich mit Corynebacterium ulcerans – einem engen Verwandten des Diphtherie-Erregers des Menschen – infizieren. Bisher waren nur vereinzelte Fälle aus Deutschland bekannt.
Bakteriologie
Urinprodukte als Lockstoffe im Jägereibedarfshandel
Lockmittel werden vielfach und in diversen Varianten im Internet als Jägereibedarf angeboten. Dabei kann es sich um synthetische Produkte, Naturstoffe (Urin, Sekrete etc.) oder Gemische aus beidem handeln.
Bakteriologie
Corynebacterium ulcerans – ein bisher wenig beachtetes humanpathogenes Bakterium beim Igel
In mehreren Bundesländern wurde bei heimischen Igeln das Bakterium Corynebacterium ulcerans – ein enger Verwandter des Diphtherie-Erregers des Menschen – nachgewiesen.